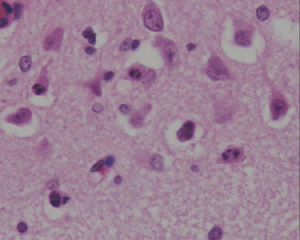

Developmental Neuropathology
Chapter 21: Grey Matter Lesions
Grey matter lesions in neonates present a wide spectrum of pathological and clinical manifestations depending on pattern, timing, and etiology. Common etiology is hypoxic-ischemic injury, but also materno-fetal infection.
Hypoxic-Ischemic Injury
- ranges from
- intrauterine chronic, partial HII from impaired placental function, preeclampsia, maternal infection or IUGR
- intrauterine sudden, severe HII in uterine rupture, placental abruption, cord prolapse
- postnatal chornic, partial HII from severe anemia, sepsis, prolonged ventilation
- postnatal sudden, severe HII in cardiac arrest, status epilepticus
- age affects type of insult/injury
- immature babies more prone to complications and prolonged HII
- gestational age related to pattern of HII secondarily
- possible relationship to changing neurotransmitter distribution
- possible relationship to metabolic activity at developmental stage
- possible relationship to myelination level at developmental stage
- most commonly involved areas are the cortex, basal ganglia, thalamus, hippocampus
- grading correlating to cognitive and motor outcome:
- mild - lentiform and thalamus
- moderate - lentiform, thalamus, central cortex
- severe - lentiform, thalamus, central cortex, hippocampus
- moderate and severe forms lead to microcephaly
Cortical lesions
- first stage is perivascular pallor due to angiogenic edema and vacuolation of cytoplasm
- swelling subsides after 7 days
- nuclear pyknosis present after a few hours
- cytoplasmic eosinophilia and lysis of nuclear membrane (necrosis) of pyramidal neurons
- apoptotic cells present with pyknotic nuclei (shrunken, basophilic) which later fragments into multiple rounded, basophilic apoptotic bodies
- early microglial reaction, later reactive macrophages (few days)
- thickened endothelial cells with rounded nuclei, capillary proliferation in a week
- reactive gliosis - begins several days post-insult
- mineralization - 10-12 days post-insult, in macrophages, axons, and neuronal cell bodies
Watershed Infarcts
- infarction of parasagittal cortex between anterior, middle, and posterior cerebral arteries
- common in asphyxiated term infants
- manifests as ulegyria
- from prolonged hypoxic-ischemic insult

Central (peri-rolandic) cortex
- bordering central sulcus and underlying white matter
- seen in term HII, not in preterm
- associated damage to basal ganglia
Hippocampus

- associated with other grey matter areas
- in adults, CA1 and CA3 of Ammons horn and the hilum of the dentate gyrus most commonly affected
- reactive gliosis and neuronal loss
- hippocampal sclerosis usually occurs in damage at < 4yrs age, but > 28wks GA
- also targeted in seizures
Dentate microglial reaction
- HII before 8-9 months of life
- dense microglial collections beneath dentate gyrus
Ponto-subicular necrosis
- apoptotic cell damage in the pons and subiculum




Ulegyria
- preferential damage of cortical sulci with preservation of gyri
- rare in adults but characteristic of term HII, especially in watershed areas


columnar cortical damage
- only described in rat models of HII, around term, related to immature cortical vascular supply
- distal gliosis
Deep grey nuclei
- bilateral lesions of basal ganglia and thalamus found in most children with cerebral palsy and severe acute HII at term
- most metabolically active areas in term infants
- especially ventro-lateral nuclei of thalamus and posterior lentiform nuclei
- associated with edema and nuclear pyknosis in the posterior limb of the internal capsule (PLIC)
- acute phase - dusky, red-brown discoloration from vascular congestion/proliferation
- chronic phase - firm, white, gliotic with tiny cystic cavities, widening of 3rd ventricle
- histology similar as above
- neurons with eosinophilia, nucleolysis and necrosis
- glial cells pyknotic and karyorrhectic
- gliosis and neuronal loss with mineralization of neurons


- Status marmoratus
- marbled appearance of deep nuclei after 6 months of age
- also seen on MRI
- result of term damage with gliosis and aberrant myelination of glial fibers
- thalamic damage in PVL
- in severe PVL in premature infants
- small areas of abnormal signal in the posterior dorsal thalamus, unlike term infants
- pathology of this not described
Cerebellum
- well-recognized HII pathology, but not as well seen on imaging (some cerebellar atrophy)
- cortex and dentate nucleus of the cerebellum is vulnerable to HII damage
- dentate - neurons die of necrosis, resulting gliosis
- cortical damage in the depths of major folia ("centrilobular pattern")
- apoptosis of the granular cells, Purkinje cells die of necrosis
- if cerebellar damage early, can be associated with failure of development of inferior olivary nuclei
Brainstem
- early maturation of brainstem nuclei means they are vulnerable to injury from early stage
- clinical syndromes include Möebius syndrome (facial diplegia, oculomotor paresis)
- "cardiac arrest encephalopathy" - severe ischemia from cardiac arrest, rare in adults
- symmetrical necrosis of the dorsal tegmentum from lower meddula up to thalamus
- high mortality
Spinal cord
- in cases of severe cerebral edema, there can also be upper cervical cord swelling and hemorrhagic necrosis
- trauma to cord from complicated delivery also described
Secondary Malformations of the Grey Matter
- secondary malformations occur when a structure is damaged early in its formation
- e.g., neuronal heterotopia, polymicrogyria, olivary dysplasia
- later insults - cortical dysplasia or hippocampal mossy fiber sprouting
- MRI studies show enhanced growth in areas adjacent to infarction
Early secondary malformation
- includes early brain damage from amniocentesis at 16-19wks GA, resulting in severe focal dysplasia and neuronal heterotopia in underlying white matter
e.g. damage to upper brain stem showed unilateral atrophy of pyramidal tracts and simplified inferior olives
- Polymicrogyria
- occurs after neuronal migration up to 28 wks GA
- can occur at the borders of infarcts (in penumbra) and CMV infection (vascular insufficiency)
- Schizencephaly
- destructive lesion before 28 wks GA, can be associated with polymicrogyria and neuronal heterotopia
- some reports of familial occurrence, but unclear genetic origin
Late secondary malformation
Acquired cortical dysplasia
- can occur in ischemic injury in teh pernatal period
- cortex bordering ischemic area can show giant neurons, loss of lamination, clustering of neurons, and bundles of myelinated fibers in the cortex
- represents reorganization of cortex leading to epilepsy and cognitive impairment
Hippcampal sclerosis
- reorganization after insults in the first years of life
- loss of neurons espeically from CA1 and hilar regions of hippocampus, and dentate gyrus
- other changes:
1. Granule cell dispersion: cell loss, gliosis and disportion of cells of granule cell layer. Can also show bilaminar dentate. Seizurs may promote hippocampal neurogenesis leading to the dispersion.
2. Mossy fiber sprouting: granule cell mossy fibers proliferate through the dentate granule cell layer, resulting in new aberrant circuits (more seizure activity)
3. Cytoskeletal abnormalities: balloon cells, accumulation of neurofilaments and dendritic alterations
Hypoglycemia
- few studies on pure hypoglycemia since it usually accompanies other insults including asphyxia
- immature brain is resistant to hypoglycemic damage due to ability to use alternate energy sources
- predominant involvement of grey matter and superficial cortical neurons
- imaging shows localization to cortex and white matter of posterior parietal and occipital lobes
- white matter damage may be secondary to cortical damage or also related to damage in intrauterine life in a diabetic mother